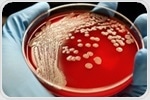
Study shows genetic mutations allow MRSA to develop antibiotic resistance

|
|
|
| |

|
|
| |
The latest Genetics news from News Medical |
|
|
|
|
|
 | | |  Globally, the rising water temperatures caused by pollution and global warming have impacted the coral reefs that are dwindling at an alarming speed. Globally, the rising water temperatures caused by pollution and global warming have impacted the coral reefs that are dwindling at an alarming speed. | | | | | Researchers have discovered that genetic mutations that occur in MRSA enable it to evolve and turn out to be more resistant to antibiotics like penicillin. Researchers have discovered that genetic mutations that occur in MRSA enable it to evolve and turn out to be more resistant to antibiotics like penicillin. | | | | |  Neuroscientists of the University of Zurich shed a new light on the mechanisms responsible for familial migraine: They show that a genetic dysfunction in specific brain cells of the cingulate cortex area strongly influences head pain occurrence. Neuroscientists of the University of Zurich shed a new light on the mechanisms responsible for familial migraine: They show that a genetic dysfunction in specific brain cells of the cingulate cortex area strongly influences head pain occurrence. | | | | |  In a new study published today in the journal Nature Medicine, researchers behind the Healthy Nevada Project® suggest that community-based genetic screening has the potential to efficiently identify individuals who may be at increased risk for three common inherited genetic conditions known to cause several forms of cancer and increased risk for heart disease or stroke. In a new study published today in the journal Nature Medicine, researchers behind the Healthy Nevada Project® suggest that community-based genetic screening has the potential to efficiently identify individuals who may be at increased risk for three common inherited genetic conditions known to cause several forms of cancer and increased risk for heart disease or stroke. | |
|
|
|
|
|